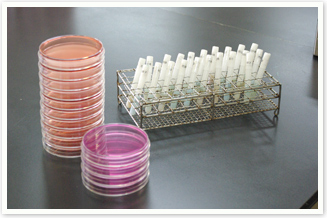

衛生検査の種類
- 寄生虫学的検査
- 蟯虫卵検査
- 微生物学的検査
- 腸内病原菌検査
- レジオネラ属菌検査
- 食材検査
- ノロウィルス検査
- ふきとり検査
- 生化学的検査
- 尿検査
- 便潜血検査

- 富士商事株式会社
- 〒990-0831
山形県山形市西田2丁目24番46号
本社 TEL.023-643-6711 FAX.023-643-6710
衛生検査所 TEL.023-643-6712 FAX.023-643-6715
- 富士商事株式会社【青森営業所】
- 〒030-0113
青森県青森市第二問屋町3丁目24番1号
TEL.017-739-5319 FAX.017-739-5323


